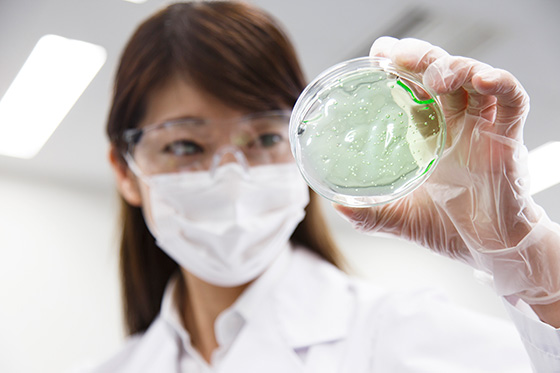

致辞
当今生物科技正迅猛发展,目前该领域正开始向信息、化学、制药、食品、纸浆、纤维机械等各种服务扩展。可以毫不夸张地说,21世纪是生物的时代。
但现在这个世界,生物科技一词仿佛与我们的生活依然相去甚远。目前生物技术还只是应用于医疗和农业产业领域,如基因药物开发及转基因食品等。

在这种情况下,我们从基因保存服务业务起步,凭借最尖端的技术积极开展活动,旨在提供更贴近生活的产品服务。我们开展活动的目的不是提供技术,而是综合性地提供具有实用性的服务、咨询和讯息。
今后本公司将突破生物技术一词汇及领域的界限,作为能够帮助大家提高健康水平、健康护理甚至于人生品质的企业,不断与大家开展对话,重视交流沟通,努力提供高品质的服务。
如果最新的生物技术不能为人所用、不为大家的生活做贡献,那么便没有意义。我们在追求最尖端技术的同时,作为大家的健康、医疗和信息咨询服务供应商,不断努力开发和提供更好的服务。






